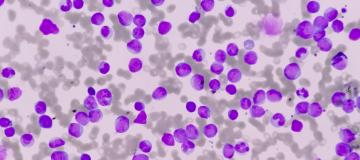
leukaemia under the microscope

Early spring: alpine conifers gain two weeks of growth in 200 years
18.02.2026
A study coordinated by the University of Padua, using frost rings, indicates a 200-year reconstruction showing an advance in the start of wood growth by about 7 days per century, which is less than the advance in buds and flowering